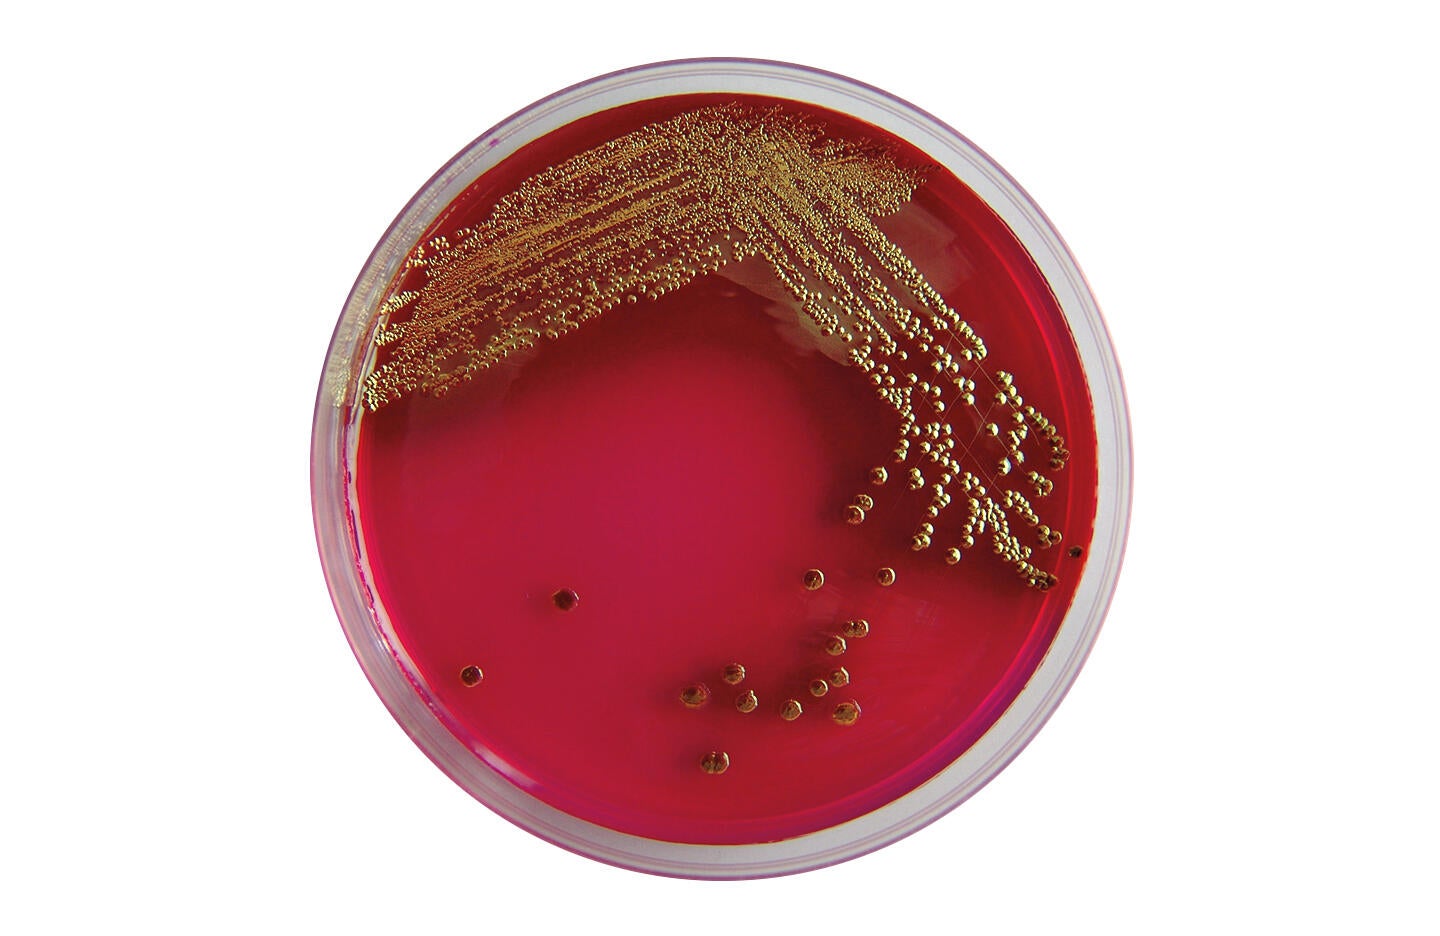

Эшерихия коли в посеве
1 лидер команды это
Клетка для летяга
Как делать поделки 6 лет
Слушать сборник хард рока
Сайт города бирска
Марты ю на карте
Мод на ттт
Попадает ураза байрам
Английский язык спотлайт 9 класс страница 20
Урсофальк видаль
Наблюдение за использованием в речи синонимов антонимов
Выполнить фонетический разбор слова дают
Synology webdav
Эшерихия коли в посеве 115 фото